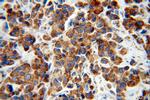
IRS1 Antibody in Immunohistochemistry (Paraffin) (IHC (P))

Search
Proteintech
IRS1 Polyclonal Antibody
{{$productOrderCtrl.translations['antibody.pdp.commerceCard.promotion.promotions']}}
{{$productOrderCtrl.translations['antibody.pdp.commerceCard.promotion.viewpromo']}}
{{$productOrderCtrl.translations['antibody.pdp.commerceCard.promotion.promocode']}}: {{promo.promoCode}} {{promo.promoTitle}} {{promo.promoDescription}}. {{$productOrderCtrl.translations['antibody.pdp.commerceCard.promotion.learnmore']}}
产品信息
17509-1-AP
种属反应
已发表种属
宿主/亚型
分类
类型
抗原
偶联物
形式
浓度
规格
纯化类型
保存液
内含物
保存条件
运输条件
产品详细信息
Immunogen sequence: EYVNIEFGS DQSGYLSGPV AFHSSPSVRC PSQLQPAPRE EETGTEEYMK MDLGPGRRAA WQESTGVEMG RLGPAPPGAA SICRPTRAVP SSRGDYMTMQ MSCPRQSYVD TSPAAPVSYA DMRTGIAAEE VSLPRATMAA ASSSSAASAS PTGPQGAAEL AAHSSLLGGP QGPGGMSAFT RVNLSPNRNQ SAKVIRADPQ GCRRRHSSET FSSTPSATRV GNTVPFGAGA AVGGGGGSSS SSEDVKRHSS ASFENVWLRP GELGGAPKEP AKLCGAAGGL ENGLNYIDLD LVKDFKQCPQ ECTPEPQPPP PPPPHQPLGS GESSSTRRSS EDLSAYASIS FQKQPEDRQ (895-1243 aa encoded by BC053895)
靶标信息
IRS-1, a major substrate of the insulin receptor, is phosphorylated in response to stimulation of cells by insulin, insulin-like growth factor 1 (IGF-1) and interleukin 4 (IL-4). IRS-1 is phosphorylated on serine, threonine and tyrosine residues in a variety of tissues. An insulin-sensitive serine/threonine kinase casein kinase II mediates a portion of the insulin-stimulated serine/threonine phosphorylation of overexpressed IRS-1 in vivo. Thr 502 is identified as the major casein kinase II-catalyzed phosphorylation site in rat IRS-1, and Ser 99 is an additional phosphorylation site catalyzed by casein kinase II. Thus, casein kinase II-catalyzed phosphorylation of IRS-1 may be a component of the intracellular insulin signaling cascade. IRS-1 contains three putative binding sites for 14-3-3 (Ser 270, Ser 374 and Ser 641) and the motif around Ser 270 is located in the phosphortyrosine binding domain of IRS-1, which is responsible for the interaction with the insulin receptor.
仅用于科研。不用于诊断过程。未经明确授权不得转售。
生物信息学
蛋白别名: Insulin receptor substrate 1; IRS-1
基因别名: HIRS-1; IRS1
UniProt ID: (Human) P35568
Entrez Gene ID: (Human) 3667